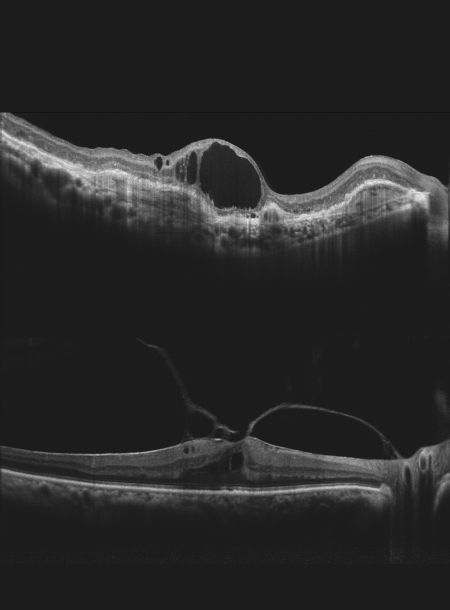
High quality OCT image
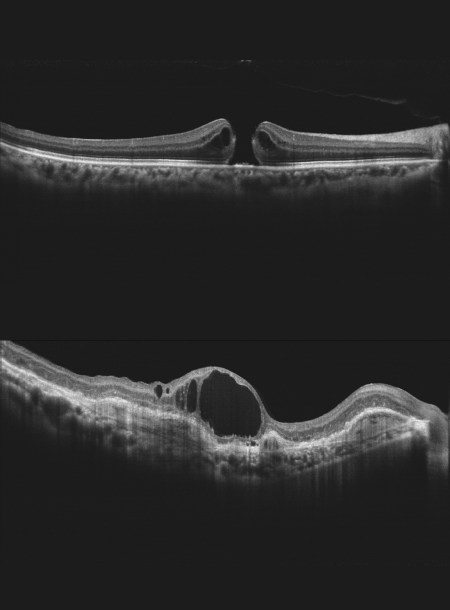
Super luminescent diode (SLD), 840 nm

Оптичний Когерентний Томограф Mocean 3000 Moptim

Mocean 3000 – це ОКТ з усіма необхідними функціями дослідження як сітківки, так і переднього відрізка ока.
Основні характеристики
- Висока якість ОКТ-зображення
- Глибина сканування 3 мм показує деталізоване зображення склоподібного тіла, сітківки та судинної оболонки
- Зображення сітківки в режимі реального часу під кутом 45° SLO
- Відстеження сітківки на основі SLO
- Сканування від кута до кута 16 мм
- Комплексний аналіз сітківки, глаукоми та рогівки
Функції програмного забезпечення для аналізу завжди актуальні та безкоштовні для оновлення (за винятком модуля OCTA).

Висока якість SLO в реальному часі + відстеження руху очей
Mocean® 3000 одночасно отримує ОКТ-зображення і зображення очного дна під кутом 47 градусів на основі скануючого лазерного офтальмоскопа (SLO), забезпечуючи огляд сітківки в режимі реального часу, що дозволяє легко локалізувати ділянку ураження ще до отримання зображення.
Щоб мінімізувати викривлення, спричинені зміщенням очей і мікросаккадами, Mocean® 4000 використовує систему відстеження очей на основі SLO.

Аналіз від кута до кута 16 мм
Сканування від кута до кута 16 мм переднього відрізка з аналізом даних.

Режим глибокої судинної томографії (DCI)
Використання глибокої судинної томографії для виявлення неоваскуляризації судинної оболонки.

Комплексний аналіз програмного забезпечення та безкоштовне оновлення
Система Mocean® 3000 пропонує 8 моделей сканування, які допоможуть вам підвищити ефективність діагностики:
Сітківка (HD лінійне та шестилінійне сканування, мульти, 3D куб),
Глаукома (Диск глаукоми для аналізу ONH, сканування макулярної області для аналізу GCC),
Рогівка (HD лінійне та шестилінійне сканування, сканування від кута до кута)
Технічні характеристики
ОКТ візуалізація | |
| Метод | Спектральна область ОКТ |
| Оптичне джерело | Суперлюмінесцентний діод (SLD), 840 нм |
| Швидкість сканування | 50 000 А-сканів/с |
| Осьова роздільна здатність (оптична) | 5 мкм (оптична), 2,7 мкм (цифрова) |
| Повздовжня роздільна здатність | 15 мкм (оптична), 3 мкм (цифрова) |
| Глибина А-сканування | 3,1 мм |
| Діапазон діоптрій | -20 до +20 D |
| Шаблони сканування | Макулярна область: Лінійне сканування HD (6 / 12 мм), 3D-сканування (6 мм x 6 мм), 6-рядкове радіальне сканування, Multi (X-Y: 5 x 5) Диск: 3D-сканування (6 мм x 6 мм) Передній відрізок: HD-лінійне сканування (6/16 мм), 6-лінійне радіальне сканування |
Зображення очного дна | |
| Метод | Лінійна скануюча лазерна офтальмоскопія (LSLO) |
| Мінімальний діаметр зіниці | 3,0 мм |
| Поле зору | 45 ± 1° |
Пристрій | |
| Зовнішні розміри | 532 мм (Д) x 360 мм (Ш) x 540 мм (В) |
| Вага | 30,5 кг |
| Частота | 50 Гц - 60 Гц |
| Вхідна потужність | 90 ВА |
Інше обладнання
Лікувальне обладнання

Категорія IPL + LLLT об'єднує сучасні технології світлотерапії для ефективного лікування сухого ока та інших захворювань ока. Комбіноване лікування дає стійкий результат, є безпечним, безболісним і добре переноситься пацієнтами.
Детальніше
Діагностичне обладнання

Допомагає офтальмологам діагностувати захворювання очей. Дозволяє проводити точніші та надійніші дослідження, а також підвищує ефективність лікування пацієнтів.
Детальніше
Ультразвукове обладнання

Використовується для діагностики та лікування захворювань очей, таких як катаракта, глаукома та діабетична ретинопатія. Воно дозволяє проводити більш точну та надійну діагностику, а також лікування пацієнтів без інвазивних процедур.
Детальніше
Лазерне обладнання

Використовується для лікування різних захворювань очей. Воно дозволяє проводити точковий та максимально малоінвазивний вплив на захворювання, що мінімізує ризики та прискорює процес одужання.
Детальніше
Лінзи діагностичні, лазерні та хірургічні

Для діагностики та лікування захворювань очей, таких як катаракта, астигматизм, далекозорість та короткозорість. Лінзи можуть бути використані для корекції зору або фокусування лазерного променя при хірургічних втручаннях.
Детальніше
Хірургічне обладнання та витратні матеріали

Включає в себе широкий спектр спеціалізованих матеріалів, що використовуються в практиці офтальмологічної медицини. Розділ охоплює різноманітні засоби, які допомагають проводити діагностику, лікування та профілактику захворювань ока.
Детальніше
Меблі офтальмологічні

Спеціально розроблені для забезпечення комфорту та безпеки пацієнтів та персоналу під час проведення процедур. Мають ергономічний дизайн і можуть бути налаштовані під індивідуальні потреби кожного лікаря та пацієнта.
Детальніше
Обладнання для оптичної майстерні

Включає інструменти для обробки та виготовлення лінз, оправ та інших оптичних виробів. Серед обладнання інструменти, необхідні для якісного виготовлення окулярів.
Детальніше